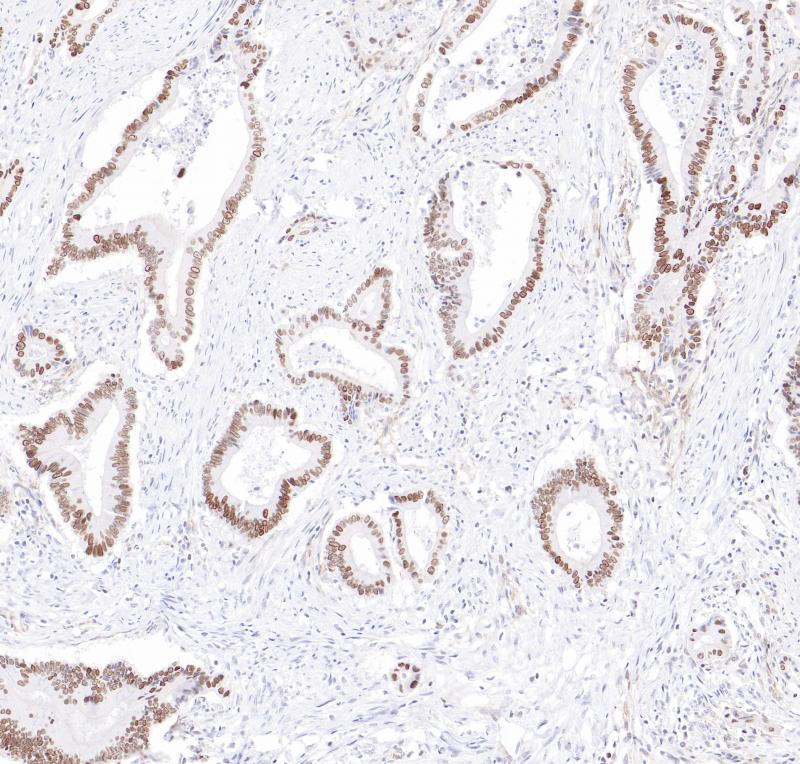
结肠癌OVOL2（BP6285）染色

产品中心
结肠癌OVOL2(BP6285)染色
OVOL2 重组兔单克隆抗体
转录因子OVO-like zinc finger 2(OVOL2)包含一个C2H2锌指四分体的锌指结构域,具有可变的N端和C端延伸,起到转录调控的作用。OVOL2在维持上皮谱系的特性中起关键作用。它还通过直接抑制MYC和NOTCH1来抑制细胞周期和角化细胞的终末分化。OVOL2在人类正常组织的睾丸、卵巢、心脏和骨骼肌中表达。研究表明OVOL2是一种结直肠肿瘤抑制因子,通过阻断WNT信号传导来减少结直肠肿瘤的进展和转移。此外,OVOL2被证明可以直接抑制几种糖酵解基因的表达,阻断Warburg效应和乳腺肿瘤的生长和转移。
Specifications
- 目录号
- BX50308
- 克隆号
- BP6285
- 阳性对照
- 结肠癌
- 亚细胞定位
- 细胞核
- 组织类型
- FFPE
- 修复方式
- HIER
- 稀释比
- 1:100-1:200
- 规格
- 100μl/vial, 1ml/vial
- 用途
- RUO
Reference
1. Ye GD, Sun GB, et al. Gastroenterology. 150(3): 659-671, 2016 Mar.
2. Zhang X, Luo F, et al. Adv Sci (Weinh). 9(27), 2022 Sep.


